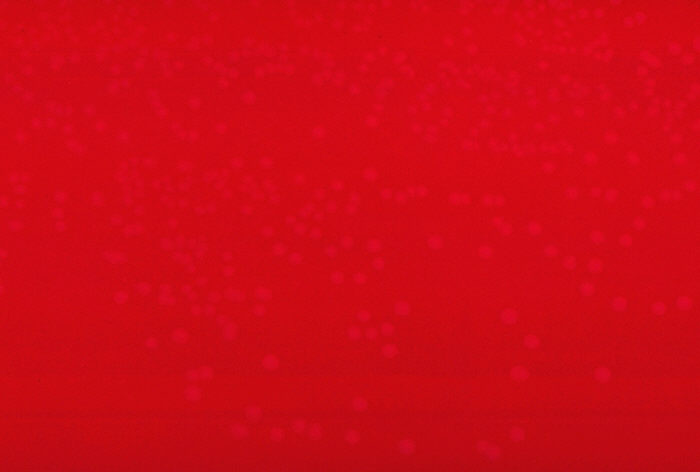
Blood agar plate culture of Erysipelothrix rhusiopathiae.

Public Domain Picture: Blood agar plate culture of Erysipelothrix rhusiopathiae.
By: CDC/ Dr. W.A. Clark, Courtesy: Public Health Image Library
Views: 254 | Downloads: 2
This work, identified by PublicDomainFiles.com, is free of known copyright restrictions.
Title:
Description:
Blood agar plate culture of Erysipelothrix rhusiopathiae.
Creator:
CDC/ Dr. W.A. Clark
Source:
Views:
254
Downloads:
2
Date Added:
November 8, 2012
Download: Largest
Size: 700 x 472
File size: 22.2 KB
File type: jpg
File size: 22.2 KB
File type: jpg
Free

Why is this picture in the Public Domain?
Produced by United States Government
The file available on this page is a work of the United States government. A work of the United States government, as defined by United States copyright law, is "a work prepared by an officer or employee of the U.S. government as part of that person's official duties." In general, under section 105 of the Copyright Act, such works are not entitled to domestic copyright protection under U.S. law.


How may I use a Public Domain picture?
The file available on this page in the Public Domain. Files in the public domain have no restrictions on use and may be used for any purpose, without any conditions, commercial or not, unless such conditions are required by law.Possible Prohibited Uses
Although a file is in the public domain, the work may still have some restrictions for use if it contains any of the following elements:
- File contains an identifiable person and such person has not provided a model release.
- File contains an identifiable building or structure and the owner of such building has not provided a property release.
- File contains a registered corporate logo or trademark.
Download Agreement
By downloading this file, you indicate that you understand and agree to all of these terms and assume full liability for your use of the file(s) and agree to hold publicdomainfiles.com harmless should any liability arise.
Home | File Sources | Frequently Asked Questions | Contact Us | Privacy Policy | © 2012-2014 publicdomainfiles.com
